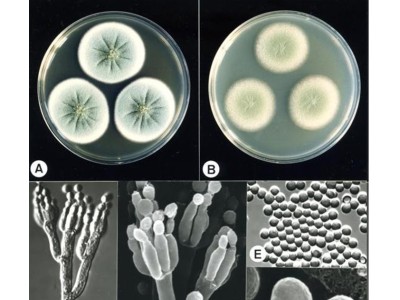

20.09.2021
10368
Грибная коррекция сосудистых нарушений.
Сердечно - сосудистые заболевания представляют собой группу болезней сердца и кровеносных сосудов:
гипертония (высокое кровяное давление)
ишемическая болезнь сердца (ин..
19.09.2021
3965
Грибные препараты как средство детоксикации организма.
В настоящее время, даже если человек следует принципам здорового образа жизни, риск интоксикации из-за загрязнения окружающей среды достиг максимального значения. Практич..
26.12.2020
7495
Методика постКОВИДной реабилитации на основе продукции Центра Фунготерапии
В результате перенесенного заболевания COVID -19 организм человека сталкивается
с весьма серьезными долговременными последствиями.
Статистика, которую постепенно нака..
19.10.2020
10321
Грибные антибиотики
Ценными источниками антибиотиков являются высшие базидиомиценты. К ним относятся шампиньон луговой, агроцибе жёсткое, лаковица розовая, маслёнок обыкновенный, рядовка фио..
29.09.2020
4653
Природная фармакология: грибы против вирусов
Одной из примет пандемии коронавируса стали подскочившие цены на имбирь, лимоны и даже репчатый лук– так называемые «продукты для иммунитета». При этом цены на свежие гри..
Показано с 13 по 17 из 17 (всего 2 страниц)